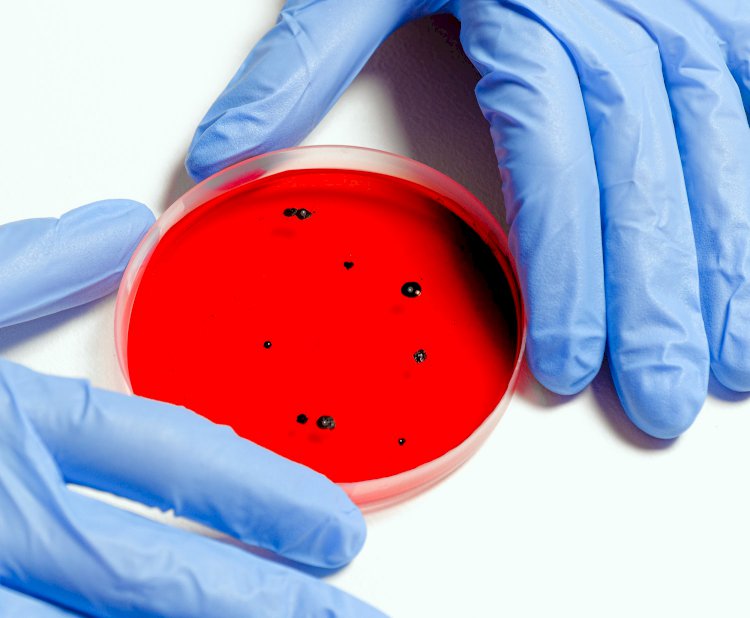
„Covid-19“ atvejų skaičius JAV viršija 4 milijonus

„Covid-19“ atvejų skaičius JAV viršija 4 milijonus
Remiantis Joneso Hopkinso universiteto duomenimis, ketvirtadienį JAV užregistruotas „Covid-19“ infekcijų skaičius viršijo keturis milijonus.
Šiuo metu JAV yra 4 005 414 infekcijos ir daugiau nei 143 800 mirčių, susijusių su „Covid-19“.
Per pastarąsias dvi savaites šalyje kiekvieną dieną buvo užregistruota nuo 60 000 iki 77 000 naujų infekcijų. Antradienį ir trečiadienį užregistruota daugiau nei 1000 naujų mirčių.
JAV užima pirmą vietą pasaulyje pagal užkrėtimus ir mirčių skaičių, o Brazilija užima antrą vietą.
Indija užima trečią vietą pagal užkrėtimus, nors mirčių skaičius yra daug mažesnis.
Joneso Hopkinso universiteto duomenimis, visame pasaulyje naujoje koronaviruso pandemijoje užregistruota daugiau nei 15,3 mln. Infekcijų ir daugiau kaip 625,800 mirčių.

 Valandos
Valandos 

























